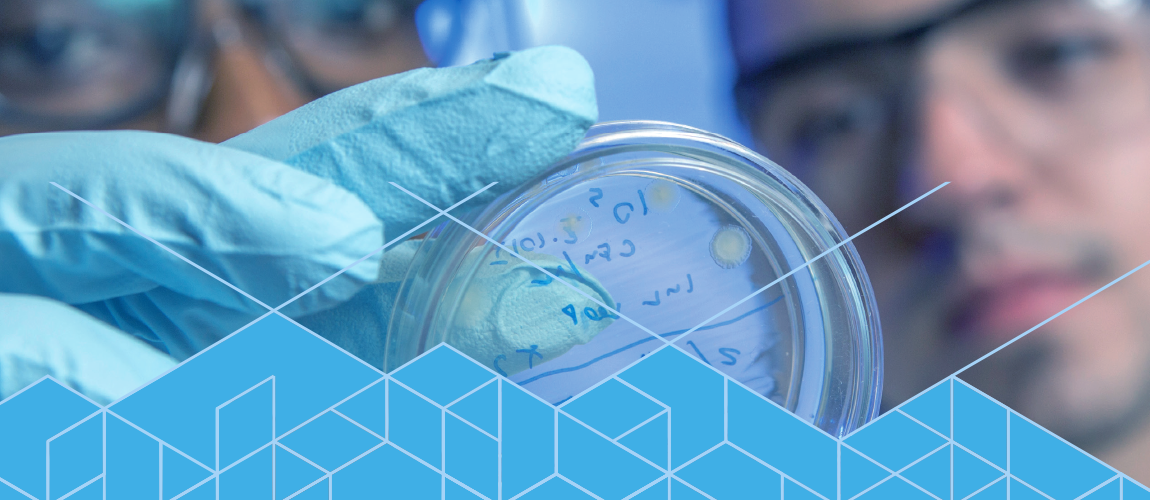

Goal 4.1 |
We will diversify and expand our fiscal resources by increasing fundraising, donations, sponsorships and/or auxiliary revenue procurement. |
Goal 4.2 |
We will increase our access to high-quality research and educational space for the benefit of all faculty, staff and students. |
Goal 4.3 |
We will recruit, retain and engage highly qualified staff and pay them at a competitive and equitable rate within Florida and the nation. |
Goal 4.4 |
We will ensure an equitable and transparent operation of the joint college by clarifying and standardizing the duties and roles for all faculty and staff. |
Goal 4.5 |
We will adopt a standardized instructional technology and cyber-infrastructure that is uniformly accessible. |

Strategic Priority 4: Operational Support